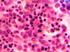
ESTUDIO HISTOPATOLOGICO BASICO DE LA MEDULA OSEA

Neoplasias Hematológicas
|
|
|
- María Teresa Casado Torres
- hace 8 años
- Vistas:
Transcripción
1 Neoplasias Hematológicas Introducción Para que se desarrolle una neoplasia es necesario un factor genético, ambiental que produzca una mutación que genera una célula aberrante, normalmente el Sistema Inmune neutraliza estas células sin embargo a veces el sistema no puede con su tarea y por lo tanto células aberrantes son exitosas en producir clonas de ella que producen una neoplasia. Para que se produzca la neoplasia es necesario que haya: 1. Mayor proliferación. 2. Alteración en la diferenciación (ej resistencia a apoptosis). La clona neoplásica produce una enfermedad que va progresando, se va extendiendo y que puede modificarse y evolucionar a formas más avanzadas. Factores predisponentes Factores genéticos : - Sd Down tienen alta probabilidad de LLA. -Ataxia Telangiectasia : Susceptibilidad de formación de lesiones por radiación. Infecciosos : Ej pacientes con enfermedades virales como: VIH: La inmunosupresión provoca aumento de neoplasias linfoides y Mieloides EBV y otros virus. Toxinas Químicos Medicamentos Tejido Hematológico Células en la Médula. Células que cubren tejido linfoide. Expresión de célula en la sangre. 1
2 Se pueden encontrar alteraciones en cualquiera de estos sitios y pueden originarse de células en distintas etapas de desarrollo, entonces una célula precursora puede dar origen a neoplasias inmaduras como es el caso de la Leucemia Aguda. Una célula madura puede dar origen a enfermedades de células maduras por ejemplo la Leucemia crónica. Recordemos también que las células tienen capacidad de diferenciarse entonces la célula neoplásica puede ser inmadura pero tiene la capacidad de diferenciarse en células maduras. Una enfermedad neoplásica como dijimos, es una enfermedad clonal por lo que se deben buscar estas clonas para dar con el Dx, la manera de buscarla es : 1. Demostrando que hay una misma alteración cromosómica en todas las células que están produciendo un tumor. 2. Buscar si hay algún re arreglo en alguna de las globulinas o en las Células T buscar su receptor, la expresión de una sola de las cadenas en neoplasias productoras de Inmunoglobulinas. Neoplasias Mieloides Básicamente tenemos 3 grandes grupos : 1. Neoplasias mieloproliferativas crónicas (NMC) : Por mucho tiempo no se consideraron neoplasias, sin embargo son producto de una expansión clonal, llevan un curso muy lento pero eventualmente pueden evolucionar a formas más agresivas de la enfermedad. 2. Sd Mielodisplásico: Se da por la producción de una clona anormal que produce células disfuncionales, de manera que la M.O produce pero no es eficiente a diferencia de las NMC. 3. Leucemias mieloides no linfocíticas: La proliferación anormal es de células inmaduras que no son capaces de madurar. Neoplasias Mieloproliferativas crónicas En la hematopoyesis la línea mieloide incluye a los precursores de linfocitos, monocitos, granulocitos y eosinófilos. Se produce dependiendo de la línea afectada,,entonces por ejemplo en la Policitemia Vera se producen en exceso los 3 (Glóbulos rojos, plaquetas y leucocitos). La Trobocitemia esencial lo que aumenta es la línea de Megacariocitos y las plaquetas. En la Mielofibrosis lo que prolifera es tejido reticular de la médula y lo que se causa es un desplazamiento de la hematopoyesis normal. Estos precursores llegan a proliferar por lo que se encuentran lesiones en distintas etapas de evolución. Es importante en la Leucemia mieloide crónica (LMC) que fue la primera enfermedad neoplásica en la que se demostró una traslocación sistemáticaticamente presente cada vez que 2
3 está la enfermedad (tras9-22), la traslocación que da origen al gen de fusión BCR-ABL que es el que lleva a la producción descontrolada de la línea mieloide. Neoplasias mieloproliferativas crónicas De evolución crónica (décadas) donde la persona lleva una vida normal, discretamente mayores en varones, asociadas a esplenomegalia. Policitemia Vera. Hablamos de las 3 líneas celulares. Trombocitemia esencial Hablamos de la línea de los megacariocitos o sea plaquetas. Mielofibrosis o Metaplasia mieloide Al haber proliferación del tejido reticular y desplazamiento de las líneas hematopoyéticas se encuentran células inmaduras en la sangre periférica. Uno puede encontrar Eritroblastos y desviación izquierda (células normales de los granulocitos pero inmaduras ej inmaduro del neutrófilo que mieloblasto) que también se le llama desviación en escalera. Eritoblastos + Desviación a izquierda = Leucoeritroblastia Entonces la Leucoeritroblastia es sinónimo de médula ósea ocupada, en este caso ocupada por fibrosis pero podría ser por un tumor sólido ejemplo una carcinomatosis medular o infección por hongos, también se ve esta condición cuando hay una reacción de médula violenta por ejemplo en una sepsis severa o una hemólisis grave. En LMC lo que prolifera es la línea mieloide, por lo que se encuentra la desviación a la izquierda pero sin los eritroblastos, puede ser desviación al a izquierda + leucocitosis. Se puede ver leucocitosis y desviación a la izquierda no patológica en condiciones de infecciones o uso de medicamentos que causan leucocitosis (esteroides). Por qué consulta alguien con una Policitemia Vera? Isquemia: Al aumentar los glóbulos rojos mucho, la circulación se compromete. Problemas a nivel de SNC. Cansancio, fatiga, letargo. Picazón post bañarse. 3
4 Por qué consulta un paciente con Trombocitemia esencial? Trombosis Sangrado anormal Estas enfermedades son crónicas con células normales, se debe tener un DxDf de una patología aguda, ejemplo una trombocitosis no neoplásica se ve en: -Infección. -Respuesta a sangrado. -Respuesta a inflamación. Al mes o 2 meses ya están normales o cuando se elimine el cuadro infeccioso. Caso: Paciente con Leucocitosis,esplenomegalia,desviación a la izquierda y dolores óseos. Se piensa en LMC, se diagnostica con un cariotipo o demostrando la traslocación del cromosoma Filadelfia (9:22) En Policitemia Vera,Trombicitemia Esencial y Mielofibrosis hay varias alteraciones moleculares pero ninguna patognomónica. Básicamente en estas patologías para el Dx se pide hemograma, clínica y biopsia de Médula ósea, en la mielofibrosis debe ser biopsia estrictamente en lugar de aspirado, porque por la fibrosis no sale la médula ( La dra dice que el Dx se puede dar por esto). Hemograma 1)No se deben ver eritroblastos normalmente : Puede ser por una reticulocitosis muy marcada o están saliendo parte de un cuadro mielocupante: Si encontramos Metamielocitos, bandas y eritroblastos, estamos frente a un cuadro leucoeritroblástico. 2)Hemograma con bastantes eritrocitos y con clínica de petequias, pensamos en trombocitemia esencial. 3)Podemos ver también Dacriocitos (GR en forma de lágrima) que traducen que la MO sufre y al GR le cuesta salir, este es un hallazgo típico de la mielofibrosis o de un síndrome mielodisplásico y a veces en anemia megaloblástica. 4
5 Síndrome Mielodisplásico Trastorno adquirido de la MO donde las células normales son reemplazadas por una clona displásica incapaz de madurar normalmente, la tasa producción en general es normal (hay excepciones) pero la calidad o el resultado es malo. Si se envía una biopsia de MO se verá muy celular pero en el hemograma se verán citopenias en cualquiera de sus combinaciones en 1,2,ó 3 líneas afectadas. Clasificación -Anemia refactaria: producción es la de la línea eritroidea. -Mielodisplasia con deleción del brazo corto del cromosoma 5 : que produce anemia. -Citopenia refractaria con displasia multilineal : Al menos 2 líneas afectadas. -Citopenias refractarias con sideroblastos en anillo: (Sideroblastos son eritroblastos con hierro) en condiciones normales no deberían estar en otro sitio que no sea médula, eventualmente el hierro queda atrapado en las mitocondrias de manera que forma un anillo. -Cuando hay aumento del porcentaje de blastos 5-9% se llama Anemia refractaria con exceso de blastos tipo 1 y cuando es mayor al 10-19% es tipo 2. -La mielodisplasia típicamente produce anemia macrocítica porque la producción es anormal Qué pasaría si alguien tiene más de 20% de blastos? Se dice tiene una leucemia aguda, si tiene menos del 5% es Síndrome mielodisplásico. Características Aumenta la incidencia con la edad, no es común en niños, progresa lentamente y la progresión es hacia Leucemia Aguda, progresan los pacientes con criterios de mal pronósticos: Mutaciones asociadas a la condición o muchos blastos al inicio. Citología El núcleo es anormal, los granulocitos son granulados o desgranulados, se ven grandes,puede haber displasia de línea eritroide con mucho citoplasma y además son binucleado, pueden haber anormalidades en la segmentación de los neutrófilos. Hemograma Macrocitosis Neutrófilos hipogranulados o degranulados. Plaquetas grandes. Alteración en granularidad 5
6 Pseudo-Pelger-Huet El pseduo Pelger-Huet se refiere a la anormalidad en el núcleo de las series granulocíticas (diferencia del Pelger Huet propiamente). *Anillos de Cabo (no se escucha bien) : Remanente del huso mitótico, podía verse en pacientes con mielodisplasia. Leucemia aguda no linfocítica Se refiere a todos los precursores de esa línea que no es linfocítica, pueden ser precursores: indiferenciados, mieloides, mieloides más diferenciados, monocíticos, mielomonocíticos, eritroleucemias y leucemias de megacariocitos, dependiendo del precursor que este proliferando. Por definición debe tener más de 20% de blastos, si es menos del 20% es mielodisplasia. La clasificación según fenotipo del predecesor precedió a la actual de la OMS, la actual o sea la de la OMS agrega alteraciones moleculares tradicionalmente, entonces hay unas de buen pronóstico ejemplo la traslocación es patognomónica de leucemia por Promielocitos que es una leucemia en la que predominan los Promielocitos que son muy granulares, estos gránulos desencadenan la activación de factores de coagulación y de ahí la CID por lo que el paciente muere por un trastorno de trombosis o de sangrado. Hace unos años se desarrolló un derivado de la vitamina A que se encarga de madurar esos Promielocitos inmaduros, antes se usaba quimio que producía la desgranulación de estos, si se usa el tratamiento de vitamina A eventualmente se controla la CID. La traslocación 8-21 se presenta en Leucemia aguda no linfocítica, la inversión 16 también y en general son mutaciones de buen pronóstico. Algunas son de mal pronóstico como la monosomía 7 y 5 o las mutaciones múltiples donde uno encuentra varias alteraciones cromosómicas, la mayoría de las otras o cuando no hay alteración cromosómica hay un pronóstico intermedio. 6
7 7
8 La Leucemia Aguda no Linfocítica aumenta con la edad, es más frecuentes en mayores, en y hombres. La gente consulta por infiltración a órganos (huesos, encías que son algunas razones de consulta),puede haber hepato-esplenomegalia donde lo que predomina son los leucocitos muy elevados, el paciente puede consultar por leucoestasis de circulación pulmonar porque se quedan adheridos a capilares. La leucemia prolifera en médula entonces puede causar citopenias (anemia,trombocitopenia o lecopenia) que producen sus propios síntomas como dificultad para ejercico,infecciones, sangrados entre otros. Los blastos mieloides de los linfoides son bastante distintos : -Típicamente el blasto linfoide tiene nucléolos grandes, es grande, el citoplasma es grande. -El blasto mieloide tiene los cuerpos de Auer, cuando uno encuentra estos sabe que es de tipo mieloide sin necesidad de más estudios. El diagnóstico se sospecha porque el paciente tiene sangrado, dolores óseos,disnea,viene con un hemograma que tiene citopenias y se le realiza una biopsia de médula ósea donde hay que detectar más de 20% de blastos, si se encuentran en sangre periférica igual se puede hablar de Leucemia aguda pero no siempre están. Puedo encontrar en la médula ósea más del 20 % y pocos en sangre periférica o citopenias. Neoplasias Linfoides Tenemos Leucemia linfocítica crónica (LLC), Linfomas Hodgkin y No Hodgkin,Neoplasias de células plasmáticas y Leucemia Linfocítica Aguda (LLA). La LLA es clínicamente muy similar a la Leucemia aguda no linfocítica, la sintomatología es por infiltración a los órganos o por leucocitosis o citopenias. Leucemia Linfocítica Crónica LLC es una enfermedad de gente mayor, generalmente después de los 60 años y es 2x más frecuente en hombres, evoluciona lentamente, muchas veces uno no la trata a menos que la sintomatología haga necesario el tratamiento y dependiendo de la condición del paciente. Esperamos encontrar adenopatías, esplenomegalia y en la circulación linfocitos maduros circulantes llamados Linfocitos Atípicos. Recordemos que para que se llame Leucemia debe tener una infiltración de la MO, entonces LLA significa que la médula está infiltrada, linfoma en fase leucémica significa que la médula está infiltrada por linfoma. En LLC por definición deben haber células anormales circulando en la sangre, si esto no se cumple entonces es un linfoma. LLC es lo mismo que un linfoma linfocítico, 8
9 solo que la primera está en la médula y sale a la circulación y el Linfoma linfocítico está en tejido linfoide, son exactamente la misma enfermedad. En sangre periférica veo linfocitos atípicos que corresponden a LLC o de Linfoma en fase leucémica. Los linfocitos estimulados son reactivos de enfermedades infecciosas y son DxDf por enfermedades infecciosas como EBV,Mononucleosis,VIH en fase aguda o en infecciones respiratorias. Morfología en el Hemograma -Si hablamos de blastos debemos considerar LLA o Mielodisplasia. -Si hablamos de Linfocito atípico: Linfocitos neoplásicos con morfología anormal. -Linfocitos estimulados : Reactivos a una infección. -Células en canasta: En LLC muy frecuentemente. Algunas características clínicas de pacientes con LLA es la predisposición a procesos inmunológicos incluye anemia hemolítica autoinmune y trombocitopenia de origen inmunológico, con frecuencia vienen de la LLC y de síndromes mieloproliferativos ejemplo un paciente con linfoma. Linfoma de Hodgkin (LH) Se presenta en hombres en la 3ra o 4ta década de vida (más jóvenes que LNH), se asocia a enfermedades por EBV o pacientes inmunosuprimidos sin embargo en la mayoría de los casos no hay factor predisponente. Para hablar de LH debemos encontrar células de Reed-Stemberg o de Hodgkin, se clasifica aparte pero es una neoplasia B sin embargo fue hasta poco que se supo esto por lo que el tratamiento se hizo por aparte y se sigue considerando como una clasificación válida. La cantidad de células Reed-Stemberg clasifican la severidad del LH (mayor con más células). Clínica : Adenopatías, masa mediastinal que puede ser muy grande y causar Síndrome de Vena Cava superior por la compresión, puede haber esplenomegalia y algunas características especiales son el prurito y un rash que puede preceder por meses o años a la aparición de las adenopatías y otra cosa es el dolor en ganglios producido por consumo de OH.Pacientes con enfermedad extensa tienen síntomas B (Fiebre, pérdida de peso 10% y sudoración nocturna, el paciente se acuesta y se baña en sudor), entre más localizada la enfermedad mejor pronóstico, esto es inclusive más importante que las subvariaciones del linfoma, la presencia de prurito y dolor no habla de enfermedad extensa. 9
10 El diagnóstico: En el hemograma puede que no haya nada alterado, tal vez una anemia crónica pero nada nos ayuda en el Dx, se necesita una biopsia del ganglio, si se tiene una masa mediastinal es necesario hacerlo igual, aunque lo más frecuente es la aparición en cuello y mediastino, puede aparecer en varias zonas como retroperitoneo, es muy variable. La clasificación Ann Arbor es válida para LH y LNH pero originalmente se diseñó para LH. En el estadio 3 tenemos adenopatías supra o infradiafragmágticas. En el estadio 4 incluye la afección a órganos vitales como corazón, pulmón, hígado o MO. La MO es parte del estadiaje inicial de cada paciente sin embargo no es parte del Dx a menos que esté infiltrada. Síntomas A: Paciente sin síntomas. Linfoma No Hodgkin (LNH) Más frecuente en hombres, aumenta con la edad, hay distintos factores asociados a la enfermedad como EBV, VIH, inmunosupresión, enfermedades autoinmunes (AR,LES),medicamentos, tóxicos, radiación o familiares. Son más frecuentes las neoplasias B que las T y son de mejor de pronóstico, el LNH tiene más compromiso extranodular ejemplo un paciente con adenopatías en cuello e infiltración palpebral, 10
11 el Dx de este paciente llegó por un oftalmólogo que le hizo biopsia del párpado. La presencia de síntomas B habla de enfermedad extendida, pueden infiltrar piel, tubo digestivo, SNC, pulmón por lo que obligatoriamente se necesita biopsia para ver la estirpe de la enfermedad. Clasificación de OMS Neoplasias de Células B La LLC es lo mismo que linfoma linfocítico (uno infiltra en MO y el otro en cuello,mediastino,retroperitoneo etc). Neoplasias de células maduras :Linfomas o Leucemias dependiendo de qué tan afectada esté la MO o no. Leucemias frecuentes: Linfoma Folicular,difuso de células Grandes, Linfoma de células B de mediastino. La leucemia de Burkitt tiene más de 20% de células en médula anormales mientras que el Linfoma de Burkitt es un tumor en algún ganglio o zona con células linfoides. El pronóstico y tratamiento depende de la enfermedad del paciente. Enfermedades indolentes: LLC, Linfoma folicular. Enfermedad agresiva: Linfoma difuso de células grandes y Linfoma de Burkitt y LLA o Linfoblástica. Linfomas T Enfermedades de Precursores son Leucemia o Linfoma linfoblástico T. Otras son leucemias que tienen componente T o NK que son más raras y difíciles de tratar o linfomas que tienen infiltración en piel como la Micosis fungoide y el Síndrome de Sézary. 11
12 El linfoma es una enfermedad del tejido linfoide, para definir la localización del tumores necesitan imágenes médica, hoy en día usa TAC y si embargo hay un estudio más novedoso es una tomografía con emisión de positrones donde la paciente se le da un medio que capta la actividad de células que tienen alteración de manera que se pude medir enfermedad o remante residual después del tratamiento. Categorías según tratamiento Se puede hablar de linfomas de bajo grado: Células con pocas mitosis donde predominan células que no mueren, indolentes, poco agresivo, la sobrevida es larga (años a décadas), las células tienen poca actividad sin embargo esto significa que son más difíciles de tratar o sea son enfermedades que no se curan, el tratamiento no está pensado para desaparecer la enfermedad sino para mantenerla apagada el mayor tiempo posible. Linfoma de Alto grado: El curso es agresivo, la sobrevida sin tratamiento es de meses, con tratamiento son potencialmente curables. El tratamiento suele ser más agresivo y riguroso. Ejemplos de Bajo grado: Linfoma linfocítico B, Linfoma Folicular B,Linfoma de zona marginal. Ejemplos de Alto grado: Linfoma de Células grandes, Linfoma Burkitt. El tratamiento de las malignidades hematológicas generalmente incluye quimioterapia, algunas como los linfomas incluyen Radioterapia, hoy en día se han agregado medicamentos biológicos específicos por ejemplo Anti CD20 marcador de Linfocitos B, hay inhibidores de proteosomas que afectan el crecimiento de la enfermedad. Hay casos que no incluyen tratamiento con quimioterapia como LLC que a veces no se da tratamiento o Leucemia de Promielocitos que incluye dosis muy bajas de quimioterapia y el Análogo de vitamina A En algunos casos se usa el trasplante de células madre por ejemplo enfermedades sensibles a la quimioterapia por lo que se usan dosis altas de ella y luego se rescata al paciente con células propias o hay enfermedades que producen efecto de injerto trasplantado contra el tumor, esto es básicamente que las células de la persona enferma se acostumbraron a no reaccionar contra el tumor entonces se lugar instaurar un nuevo sistema inmunológico que batalla contra el tumor. Leucemia Linfocítica Aguda Enfermedad maligna más común en niños. La mayoría se presentan en menores de 20 años, se relaciona con químicos,radiación,síndrome de Down por mencionar algunos, pero la gran mayoría de las veces se encuentran alteraciones en alguien que no se ha expuesto a estos factores de forma documentada, en síndrome de Down es más común la Leucemia B que la T.En general el pronóstico empeora con la edad y con las mutaciones con mal pronóstico ejemplo en la LLA la traslocación del cromosoma Filadelfia es indicador de mal pronóstico (principal factor). 12
13 Los blastos linfoides son células más pequeñas, más cercanas al tamaño del GR, tienen menos citoplasma, usualmente el citoplasma tiene gránulos y no tiene los nucléolos tan grandes como los que se ven en la Leucemia Mieloide Aguda. Neoplasias de Células Plasmáticas El más común es el Mieloma múltiple, normalmente se aloja en MO,cuando aparece como una tumoración se le llama Plasmocitoma, se encuentra muchas veces una producción monoclonal de algún tipo de Inmunoglobulina sin algún tipo de alteración, no se diagnostica tan frecuentemente pero si es de frecuente de encontrar. Existen otras enfermedades por depósito de inmunoglobulinas como amiloidosis y otras menos frecuentes. Mieloma Múltiple Proliferación maligna de células plasmáticas dentro de la MO, las células plasmáticas deben producir con pocas excepciones alguna proteína ya sea IgG,IgM etc o algún fragmento de globulina alguna cadena liviana típicamente, es una enfermedad del adulto, más frecuentemente en adulto mayor, cuando se producen inmunoglobulinas completas uno puede encontrar en sangre, cuando solo se producen cadenas livianas (kappa o lambda) se encuentran en orina que es lo que se conoce como proteinuria de Bence Jones. Se activa la resorción ósea mediante un factor activador de osteoclastos, el paciente llega a tener osteoporosis, lesiones líticas o fracturas patológicas, puede consultar por colapso vertebral o por anemia. La producción de Inmunoglobulinas en sangre periférica produce una apilación de GR que forman pilas de monedas, ahora es una enfermedad donde se producen Ig s sin ningún estimulo por lo que cuando se necesiten estas no se dará una respuesta necesaria por lo que se da inmunosupresión, infecciones y además neutropenia. Hay hipercalcemia por la resorción ósea, hiperviscosidad en la sangre por el exceso de Ig s, Insuficiencia Renal por la producción de cadenas livianas o depósito de proteínas que causan amiloidosis por lo que se puede afectar mucosas ejemplo la lengua se engrosa. El diagnóstico es mediante una biopsia de MO donde se debe ver infiltración por células plasmáticas, presencia de Ig s que deben ser monoclonales, pueden verse células en saca bocados. Se pide una serie ósea metastásica donde se revisan todos los huesos pero donde más frecuentemente están es en vértebras y huesos largos. * La insuficiencia Renal se puede dar por la hipercalcemia que causa deshidratación, la amiloidosis o tomar AINES porque lo consumen por el dolor. 13
ALTERACIONES GLOBULOS BLANCOS
 ALTERACIONES GLOBULOS BLANCOS Clase 3 Prof. CLAUDIA YEFI RUBIO INSTITUTO DE FARMACOLOGIA y MORFOFISIOLOGIA UNIVERSIDAD AUSTRAL DE CHILE GENERALIDADES Las Leucemias corresponden a la producción descontrolada
ALTERACIONES GLOBULOS BLANCOS Clase 3 Prof. CLAUDIA YEFI RUBIO INSTITUTO DE FARMACOLOGIA y MORFOFISIOLOGIA UNIVERSIDAD AUSTRAL DE CHILE GENERALIDADES Las Leucemias corresponden a la producción descontrolada
NEOPLASIAS HEMATOPOYETICAS
 NEOPLASIAS HEMATOPOYETICAS LINFOMA Distinguir de lesiones linfoides benignas Linfoma no Hodgkin Linfoma de Hodgkin MASTOCITOSIS SISTEMICA BIOPSIAS DE MEDULA OSEA Biopsias bilaterales (2 cm cada una) Fijación
NEOPLASIAS HEMATOPOYETICAS LINFOMA Distinguir de lesiones linfoides benignas Linfoma no Hodgkin Linfoma de Hodgkin MASTOCITOSIS SISTEMICA BIOPSIAS DE MEDULA OSEA Biopsias bilaterales (2 cm cada una) Fijación
Serie Roja. Hemograma. Hemograma 13/09/2011. Anemias Hb < 12 gr% en la mujer y 14 gr% en el hombre.
 Hemograma Serie Roja Dra. Patricia Fardella Bello Hematólogo Sección Quimioterapia Fundación Arturo López Pérez 12 septiembre 2011 Serie Blanca 3 series: Pancitopenia Serie Megacariocitica Hemograma Serie
Hemograma Serie Roja Dra. Patricia Fardella Bello Hematólogo Sección Quimioterapia Fundación Arturo López Pérez 12 septiembre 2011 Serie Blanca 3 series: Pancitopenia Serie Megacariocitica Hemograma Serie
Linfoma o enfermedad de Hodgkin. Dr. Enrique Payns Borrego
 Linfoma o enfermedad de Hodgkin Dr. Enrique Payns Borrego 1 Linfoma de Hodgkin (LH) Se forma a partir de un linfocitos B que se encuentran en proceso de maduración/activación en el ganglio linfático Sufre
Linfoma o enfermedad de Hodgkin Dr. Enrique Payns Borrego 1 Linfoma de Hodgkin (LH) Se forma a partir de un linfocitos B que se encuentran en proceso de maduración/activación en el ganglio linfático Sufre
LEUCEMIAS. LIC. MACZY GONZÁLEZ RINCÓN MgSc CÁTEDRA DE HEMATOLOGÍA ESCUELA DE BIOANÁLISIS UNIVERSIDAD DEL ZULIA
 LEUCEMIAS LIC. MACZY GONZÁLEZ RINCÓN MgSc CÁTEDRA DE HEMATOLOGÍA ESCUELA DE BIOANÁLISIS UNIVERSIDAD DEL ZULIA LEUCEMIAS: DEFINICIÓN ENFERMEDADES DE ORIGEN CLONAL DONDE SE AFECTA EL STEM CELL LINFOIDE O
LEUCEMIAS LIC. MACZY GONZÁLEZ RINCÓN MgSc CÁTEDRA DE HEMATOLOGÍA ESCUELA DE BIOANÁLISIS UNIVERSIDAD DEL ZULIA LEUCEMIAS: DEFINICIÓN ENFERMEDADES DE ORIGEN CLONAL DONDE SE AFECTA EL STEM CELL LINFOIDE O
LEUCEMIA AGUDA. Dra Ana Maria Quiroga V
 LEUCEMIA AGUDA. Dra Ana Maria Quiroga V Definición Enfermedad primaria de la médula ósea caracterizada por una alteración de la hematopoyesis, en que un progenitor ya sea linfoide, mieloide o eritroide
LEUCEMIA AGUDA. Dra Ana Maria Quiroga V Definición Enfermedad primaria de la médula ósea caracterizada por una alteración de la hematopoyesis, en que un progenitor ya sea linfoide, mieloide o eritroide
Dra Elsa Zotta
 Dra Elsa Zotta [email protected] Displasia Estos cambios pueden ser reversibles, y al desaparecer la causa inductora, el epitelio puede volver a la normalidad. 2 Displasia Una anormalidad en el aspecto
Dra Elsa Zotta [email protected] Displasia Estos cambios pueden ser reversibles, y al desaparecer la causa inductora, el epitelio puede volver a la normalidad. 2 Displasia Una anormalidad en el aspecto
3ºCongreso Bioquímico de Córdoba 2015
 3ºCongreso Bioquímico de Córdoba 2015 Dra. Graciela Lucero. Unidad de Investigaciones Oncohematológicas - Oncolab. Buenos Aires. INFECCIONES BACTERIANAS ALERGIA ENFERMEDADES INFLAMATORIAS CAUSAS NECROSIS
3ºCongreso Bioquímico de Córdoba 2015 Dra. Graciela Lucero. Unidad de Investigaciones Oncohematológicas - Oncolab. Buenos Aires. INFECCIONES BACTERIANAS ALERGIA ENFERMEDADES INFLAMATORIAS CAUSAS NECROSIS
Sindromes Mielodisplásticos
 Sindromes Mielodisplásticos Dr. Mauricio Ocqueteau T PROGRAMA DE CANCER PONTIFICIA UNIVERSIDAD CATOLICA DE CHILE Hematopoiesis Normal 1 Oncogénesis: oncogenes y genes supresores Proto-oncogenes oncogenes
Sindromes Mielodisplásticos Dr. Mauricio Ocqueteau T PROGRAMA DE CANCER PONTIFICIA UNIVERSIDAD CATOLICA DE CHILE Hematopoiesis Normal 1 Oncogénesis: oncogenes y genes supresores Proto-oncogenes oncogenes
Módulo de Patología del Sistema Hematopoyético
 Módulo de Patología del Sistema Hematopoyético Puntos agregados por una respuesta acertada: Puntos penalizados por una respuesta errónea: Ignorar los puntos de cada pregunta: 1. Un paciente varón de 40
Módulo de Patología del Sistema Hematopoyético Puntos agregados por una respuesta acertada: Puntos penalizados por una respuesta errónea: Ignorar los puntos de cada pregunta: 1. Un paciente varón de 40
Colegio Médicos y Cirujanos de Costa Rica. Seminario de Hematología 22 de Noviembre de 2014
 Colegio Médicos y Cirujanos de Costa Rica Seminario de Hematología 22 de Noviembre de 2014 1. Dentro de la fisiopatología del Síndrome de Hiperviscosidad, encontramos hallazgos de síntomas, signos y del
Colegio Médicos y Cirujanos de Costa Rica Seminario de Hematología 22 de Noviembre de 2014 1. Dentro de la fisiopatología del Síndrome de Hiperviscosidad, encontramos hallazgos de síntomas, signos y del
DE LA ALARMA DEL HEMOGRAMA AL INMUNOFENOTIPO CON PARADA OBLIGADA EN EL FROTIS
 DE LA ALARMA DEL HEMOGRAMA AL INMUNOFENOTIPO CON PARADA OBLIGADA EN EL FROTIS Luis Sáenz Mateos Residente 2º año Análisis Clínicos Hospital General Universitario de Ciudad Real Procedimiento Operativo
DE LA ALARMA DEL HEMOGRAMA AL INMUNOFENOTIPO CON PARADA OBLIGADA EN EL FROTIS Luis Sáenz Mateos Residente 2º año Análisis Clínicos Hospital General Universitario de Ciudad Real Procedimiento Operativo
REPUBLICA BOLIVARIANA DE VENEZUELA LA UNIVERSIDAD DEL ZULIA CÁTEDRA DE INMUNOLOGÍA ESCUELA DE BIOANÁLISIS
 REPUBLICA BOLIVARIANA DE VENEZUELA LA UNIVERSIDAD DEL ZULIA CÁTEDRA DE INMUNOLOGÍA ESCUELA DE BIOANÁLISIS TRASTORNOS LINFOPROLIFERATIVOS CRONICOS CLASIFICACION SEGÚN LA O.M.S NEOPLASIAS B PERIFERICAS:
REPUBLICA BOLIVARIANA DE VENEZUELA LA UNIVERSIDAD DEL ZULIA CÁTEDRA DE INMUNOLOGÍA ESCUELA DE BIOANÁLISIS TRASTORNOS LINFOPROLIFERATIVOS CRONICOS CLASIFICACION SEGÚN LA O.M.S NEOPLASIAS B PERIFERICAS:
FOSFATASA ALCALINA GRANULOCÍTICA
 Citoquímica II 2016 LMC FOSFATASA ALCALINA GRANULOCÍTICA Hidroliza monoésteres del ácido fosfórico a ph alcalino (9,1-9,6) Marcadora de la granulación específica de los neutrófilos. Actividad asociada
Citoquímica II 2016 LMC FOSFATASA ALCALINA GRANULOCÍTICA Hidroliza monoésteres del ácido fosfórico a ph alcalino (9,1-9,6) Marcadora de la granulación específica de los neutrófilos. Actividad asociada
Más allá del reporte del hemograma: pruebas de laboratorio adicionales para evaluar una neoplasia hematológica
 Más allá del reporte del hemograma: pruebas de laboratorio adicionales para evaluar una neoplasia hematológica Diapositiva 1: Esta es una versión traducida al español de la presentación hecha por el doctor
Más allá del reporte del hemograma: pruebas de laboratorio adicionales para evaluar una neoplasia hematológica Diapositiva 1: Esta es una versión traducida al español de la presentación hecha por el doctor
Congreso Nacional del Laboratorio Clínico 2015
 CITOLOGÍA DE SANGRE PERIFÉRICA Y AUTOMATIZACIÓN EN EL DIAGNÓSTICO DE LAS ENFERMEDADES HEMATOLÓGICAS MALIGNAS 8 de Octubre del 2015 Anna Merino, Cristian Morales-Indiano y Santiago Alférez 1.Cómo la citología
CITOLOGÍA DE SANGRE PERIFÉRICA Y AUTOMATIZACIÓN EN EL DIAGNÓSTICO DE LAS ENFERMEDADES HEMATOLÓGICAS MALIGNAS 8 de Octubre del 2015 Anna Merino, Cristian Morales-Indiano y Santiago Alférez 1.Cómo la citología
Leucemia. Dr. Rafael Hurtado Monroy
 1 Leucemia Dr. Rafael Hurtado Monroy Es un término que define a un grupo de enfermedades malignas de la sangre y el diagnóstico temprano es muy importante para que el paciente acuda con el especialista
1 Leucemia Dr. Rafael Hurtado Monroy Es un término que define a un grupo de enfermedades malignas de la sangre y el diagnóstico temprano es muy importante para que el paciente acuda con el especialista
Citología de la médula ósea y sangre
 Citología de la médula ósea y sangre Cristina Fernández Algarra Diagnóstico citológico veterinario. Avenida del Padre Piquer 4. 28024-Madrid. [email protected] Resumen: en la médula ósea se generan
Citología de la médula ósea y sangre Cristina Fernández Algarra Diagnóstico citológico veterinario. Avenida del Padre Piquer 4. 28024-Madrid. [email protected] Resumen: en la médula ósea se generan
Leucocitosis y Leucopenia: Diagnostico diferencial
 Leucocitosis y Leucopenia: Diagnostico diferencial Dra. Carolina Tokumura Jefe del Servicio de Hematología-Oncología Clínica Hospital Cayetano Heredia Profesor Auxiliar Universidad Peruana Cayetano Heredia
Leucocitosis y Leucopenia: Diagnostico diferencial Dra. Carolina Tokumura Jefe del Servicio de Hematología-Oncología Clínica Hospital Cayetano Heredia Profesor Auxiliar Universidad Peruana Cayetano Heredia
LINFOMA UN CÁNCER CON POSIBILIDAD DE CURA LINFOMA. Es un tipo de cáncer que se desarrolla en el sistema linfático.
 LINFOMA UN CÁNCER CON POSIBILIDAD DE CURA L LINFOMA Es un tipo de cáncer que se desarrolla en el sistema linfático. Ocupa entre el séptimo y noveno lugar en los tipos de cáncer más frecuentes en la población.
LINFOMA UN CÁNCER CON POSIBILIDAD DE CURA L LINFOMA Es un tipo de cáncer que se desarrolla en el sistema linfático. Ocupa entre el séptimo y noveno lugar en los tipos de cáncer más frecuentes en la población.
INFORMACIÓN PARA EL PACIENTE CON LMC
 INFORMACIÓN PARA EL PACIENTE CON LMC LA LEUCEMIA MIELOIDE CRÓNICA La Leucemia Mieloide Crónica (LMC) es una enfermedad neoplásica de la médula ósea, en la cual se producen una cantidadexcesiva de glóbulos
INFORMACIÓN PARA EL PACIENTE CON LMC LA LEUCEMIA MIELOIDE CRÓNICA La Leucemia Mieloide Crónica (LMC) es una enfermedad neoplásica de la médula ósea, en la cual se producen una cantidadexcesiva de glóbulos
ENFERMEDADES MALIGNAS DE LA SANGRE
 Enfermedades malignas de la sangre Page 1 sur 6 Atlas of Genetics and Cytogenetics in Oncology and Haematology ENFERMEDADES MALIGNAS DE LA SANGRE * Introducción Síndromes mieloproliferativos Leucemia mieloide
Enfermedades malignas de la sangre Page 1 sur 6 Atlas of Genetics and Cytogenetics in Oncology and Haematology ENFERMEDADES MALIGNAS DE LA SANGRE * Introducción Síndromes mieloproliferativos Leucemia mieloide
Cáncer a la Sangre, Leucemia
 Cáncer a la Sangre, Leucemia La leucemia es un tipo de cáncer que afecta a la sangre, en particular a los glóbulos blancos que son las células de la sangre encargadas de combatir las infecciones. Este
Cáncer a la Sangre, Leucemia La leucemia es un tipo de cáncer que afecta a la sangre, en particular a los glóbulos blancos que son las células de la sangre encargadas de combatir las infecciones. Este
RETINOPATIA LEUCEMICA
 RETINOPATIA LEUCEMICA Retinopatia Leucemica 1996, 27.600 casos leucemia USA. Sx oftalmologicos Dx. Enf. Sistemica. El ojo refleja el estado de la enf en el cuerpo Examen oftalmologico Extension Pronostico.
RETINOPATIA LEUCEMICA Retinopatia Leucemica 1996, 27.600 casos leucemia USA. Sx oftalmologicos Dx. Enf. Sistemica. El ojo refleja el estado de la enf en el cuerpo Examen oftalmologico Extension Pronostico.
Patología hematopoyética 1. UNIBE Patología 2 III cuatrimestre 2012
 Patología hematopoyética 1 UNIBE Patología 2 III cuatrimestre 2012 Temas Leucocitosis, leucopenia, neutropenia y agranulocitosis. Leucemias. Mielodisplasias y síndromes mieloproliferativos. Mieloma múltiple
Patología hematopoyética 1 UNIBE Patología 2 III cuatrimestre 2012 Temas Leucocitosis, leucopenia, neutropenia y agranulocitosis. Leucemias. Mielodisplasias y síndromes mieloproliferativos. Mieloma múltiple
Composición Líquido Elementos formes
 Composición Líquido Elementos formes Plasma Glóbulos blancos Glóbulos rojos Plaquetas Transporte de sustancias Homeostasis de los líquidos l corporales Protección TRANSPORTE O 2 desde los pulmones a los
Composición Líquido Elementos formes Plasma Glóbulos blancos Glóbulos rojos Plaquetas Transporte de sustancias Homeostasis de los líquidos l corporales Protección TRANSPORTE O 2 desde los pulmones a los
Guía docente de la asignatura Hematología
 Guía docente de la asignatura HEMATOLOGÍA Asignatura Materia Módulo Titulación HEMATOLOGIA FORMACION MEDICO-QUIRURGICA III: FORMACION CLINICA HUMANA GRADO EN MEDICINA Plan 2010 Código Periodo de impartición
Guía docente de la asignatura HEMATOLOGÍA Asignatura Materia Módulo Titulación HEMATOLOGIA FORMACION MEDICO-QUIRURGICA III: FORMACION CLINICA HUMANA GRADO EN MEDICINA Plan 2010 Código Periodo de impartición
CURSO DE MORFOLOGÍA HEMATOLÓGICA
 CURSO DE MORFOLOGÍA HEMATOLÓGICA Caracas, 10 de julio de 2015 Caso Clínico I.A.H.U.L.A. Mérida Alexander Manuel Arellano Rojas Médico Residente de Hematología de la ULA SOCIEDAD VENEZOLANA DE HEMATOLOGÍA
CURSO DE MORFOLOGÍA HEMATOLÓGICA Caracas, 10 de julio de 2015 Caso Clínico I.A.H.U.L.A. Mérida Alexander Manuel Arellano Rojas Médico Residente de Hematología de la ULA SOCIEDAD VENEZOLANA DE HEMATOLOGÍA
ASTURIAS, CANTABRIA, EUSKADI, ANDALUCÍA
 CANARIAS ASTURIAS, CANTABRIA, EUSKADI, ANDALUCÍA GRUPO CATEGORÍA Nº IMG 1. ANEMIAS (EXCEPTO ANEMIA APLÁSICA) 1.1. ANEMIAS CARENCIALES 1.1.1. ANEMIA FERROPÉNICA 1.1.2. ANEMIA MEGALOBLÁSTICA 1.2. ANEMIAS
CANARIAS ASTURIAS, CANTABRIA, EUSKADI, ANDALUCÍA GRUPO CATEGORÍA Nº IMG 1. ANEMIAS (EXCEPTO ANEMIA APLÁSICA) 1.1. ANEMIAS CARENCIALES 1.1.1. ANEMIA FERROPÉNICA 1.1.2. ANEMIA MEGALOBLÁSTICA 1.2. ANEMIAS
Tema 49.- Cáncer en la infancia
 Tema 49.- Cáncer en la infancia Introducción Etiología Pruebas diagnósticas Tratamiento: Cirugía, radioterapia, quimioterapia Diagnósticos enfermeros Actuación de enfermería Formas más frecuentes: leucemia,
Tema 49.- Cáncer en la infancia Introducción Etiología Pruebas diagnósticas Tratamiento: Cirugía, radioterapia, quimioterapia Diagnósticos enfermeros Actuación de enfermería Formas más frecuentes: leucemia,
INTRODUCCIÓN Linfoma Centroblástico
 INTRODUCCIÓN Los Linfomas No Hodgkin constituyen un grupo heterogéneo de neoplasias malignas linfoproliferativas con una biología y comportamiento clínico diferente. Se produjeron 55,000 casos nuevos de
INTRODUCCIÓN Los Linfomas No Hodgkin constituyen un grupo heterogéneo de neoplasias malignas linfoproliferativas con una biología y comportamiento clínico diferente. Se produjeron 55,000 casos nuevos de
LEUCOCITOS SANGUÍNEOS
 UNIVERSIDAD CENTROCCIDENTAL LISANDRO ALVARADO DECANATO DE CIENCIAS DE LA SALUD DEPARTAMENTO DE CIENCIAS FUNCIONALES LEUCOCITOS SANGUÍNEOS Lic. Ana López-Fonseca [email protected] CONTENIDO Leucocitos
UNIVERSIDAD CENTROCCIDENTAL LISANDRO ALVARADO DECANATO DE CIENCIAS DE LA SALUD DEPARTAMENTO DE CIENCIAS FUNCIONALES LEUCOCITOS SANGUÍNEOS Lic. Ana López-Fonseca [email protected] CONTENIDO Leucocitos
Orientación diagnóstica de las anemias en Urgencias. Hematología Clínica Rotger 2016
 Orientación diagnóstica de las anemias en Urgencias Definición Disminución de la hemoglobina por debajo de los valores normales Definición La hemoglobina es el parámetro más correcto para valorar una anemia
Orientación diagnóstica de las anemias en Urgencias Definición Disminución de la hemoglobina por debajo de los valores normales Definición La hemoglobina es el parámetro más correcto para valorar una anemia
MIELOMA MULTIPLE. Se manifiesta en estos pacientes, debilidad, fatiga, y hemorragias como consecuencia de una medula ósea insuficiente.
 MIELOMA MULTIPLE 1. Qué es el mieloma múltiple? Es un cáncer de unas células llamadas plasmáticas, que nacen de nuestro sistema de defensa llamado también inmunológico, éstas células que producen a las
MIELOMA MULTIPLE 1. Qué es el mieloma múltiple? Es un cáncer de unas células llamadas plasmáticas, que nacen de nuestro sistema de defensa llamado también inmunológico, éstas células que producen a las
Dra. Alejandra Rocca Asistente Hematologia
 Dra. Alejandra Rocca Asistente Hematologia GAMAPATIAS MONOCLONALES Grupo de patologías caracterizadas por la proliferación de una clona de linfocitos o células plasmáticas que producen una Ig o un fragmento
Dra. Alejandra Rocca Asistente Hematologia GAMAPATIAS MONOCLONALES Grupo de patologías caracterizadas por la proliferación de una clona de linfocitos o células plasmáticas que producen una Ig o un fragmento
CURSO DE MÉDULA ÓSEA La médula ósea para patólogos generales:
 CURSO DE MÉDULA ÓSEA La médula ósea para patólogos generales: NEOPLASIAS MIELOPROLIFERATIVAS CRÓNICAS (NMPC) Mar Garcia NMPC Transtornos hematopoyéticos caracterizados por la proliferación clonal efectiva
CURSO DE MÉDULA ÓSEA La médula ósea para patólogos generales: NEOPLASIAS MIELOPROLIFERATIVAS CRÓNICAS (NMPC) Mar Garcia NMPC Transtornos hematopoyéticos caracterizados por la proliferación clonal efectiva
Leucemia. Respuestas proliferativas anormales de los leucocitos. Alumnas: Ma Cecilia Gallardo Paulina Nauto Carrillo
 Leucemia Respuestas proliferativas anormales de los leucocitos Alumnas: Ma Cecilia Gallardo Paulina Nauto Carrillo Asignatura: Fisiopatología General Docente: Dra. Ma Gloria Pinto Miércoles, 08 de junio
Leucemia Respuestas proliferativas anormales de los leucocitos Alumnas: Ma Cecilia Gallardo Paulina Nauto Carrillo Asignatura: Fisiopatología General Docente: Dra. Ma Gloria Pinto Miércoles, 08 de junio
Neoplasia mieloproliferativa: Detección de la enfermedad con base a un patrón de reconocimiento en sangre periférica
 Neoplasia mieloproliferativa: Detección de la enfermedad con base a un patrón de reconocimiento en sangre periférica Diapositiva 1: Esta es una versión traducida al español de la presentación hecha por
Neoplasia mieloproliferativa: Detección de la enfermedad con base a un patrón de reconocimiento en sangre periférica Diapositiva 1: Esta es una versión traducida al español de la presentación hecha por
El linfoma no Hodgkin en adultos es una afección por la cual se forman células malignas (cancerosas) en el sistema linfático.
 Linfoma no Hodgkin El linfoma no Hodgkin en adultos es una afección por la cual se forman células malignas (cancerosas) en el sistema linfático. El sistema linfático es parte del sistema inmunitario y
Linfoma no Hodgkin El linfoma no Hodgkin en adultos es una afección por la cual se forman células malignas (cancerosas) en el sistema linfático. El sistema linfático es parte del sistema inmunitario y
CATEDRA DE HEMATOLOGIA DEPARTAMENTO CLINICO DE MEDICINA HOSPITAL DE CLINICAS FACULTAD DE MEDICINA GUIA PARA PACIENTES MIELOMA
 CATEDRA DE HEMATOLOGIA DEPARTAMENTO CLINICO DE MEDICINA HOSPITAL DE CLINICAS FACULTAD DE MEDICINA GUIA PARA PACIENTES MIELOMA Marzo 2010 INTEGRANTES DE LA CATEDRA QUE PARTICIPARON EN LA ELABORACION DE
CATEDRA DE HEMATOLOGIA DEPARTAMENTO CLINICO DE MEDICINA HOSPITAL DE CLINICAS FACULTAD DE MEDICINA GUIA PARA PACIENTES MIELOMA Marzo 2010 INTEGRANTES DE LA CATEDRA QUE PARTICIPARON EN LA ELABORACION DE
Tumores inmunohematopoyéticos mieloma múltiple linfoma Hodgkin linfoma no Hodgkin
 Tumores inmunohematopoyéticos mieloma múltiple linfoma Hodgkin linfoma no Hodgkin Curso de Ortopedia Oncológica y Salvamento de Extremidades Asesor: Dr. Carlos Cuervo Ponente: Dr. Alejandro Treviño R4
Tumores inmunohematopoyéticos mieloma múltiple linfoma Hodgkin linfoma no Hodgkin Curso de Ortopedia Oncológica y Salvamento de Extremidades Asesor: Dr. Carlos Cuervo Ponente: Dr. Alejandro Treviño R4
SINDROMES LINFOPROLIFERATIVOS. CICLIPA II-2011 Dra. Carolina Oliver Asistente I. de Hematología
 SINDROMES LINFOPROLIFERATIVOS CICLIPA II-2011 Dra. Carolina Oliver Asistente I. de Hematología ORGANOS LINFÁTICOS Primarios: Timo y MO. Precursores de linfocitos se transforman en especializados T y B.
SINDROMES LINFOPROLIFERATIVOS CICLIPA II-2011 Dra. Carolina Oliver Asistente I. de Hematología ORGANOS LINFÁTICOS Primarios: Timo y MO. Precursores de linfocitos se transforman en especializados T y B.
Dra. Graciela Grosso Junio 2013
 Dra. Graciela Grosso Junio 2013 Neoplásicas o potencialmente neoplásicas Proliferación clonal de plasmocitos secretantes de Ig Secreción de proteínas monoclonales -homogéneas electroforética e inmunológicamente
Dra. Graciela Grosso Junio 2013 Neoplásicas o potencialmente neoplásicas Proliferación clonal de plasmocitos secretantes de Ig Secreción de proteínas monoclonales -homogéneas electroforética e inmunológicamente
TEJIDO SANGUINEO DRA. ALEJANDRA B. QUINTANA
 TEJIDO SANGUINEO DRA. ALEJANDRA B. QUINTANA 2016 TEJIDO SANGUINEO La sangre es un tejido conjuntivo líquido que circula por el aparato cardiovascular COMPOSICIÓN DEL TEJIDO SANGUÍNEO: La sangre es un fluido
TEJIDO SANGUINEO DRA. ALEJANDRA B. QUINTANA 2016 TEJIDO SANGUINEO La sangre es un tejido conjuntivo líquido que circula por el aparato cardiovascular COMPOSICIÓN DEL TEJIDO SANGUÍNEO: La sangre es un fluido
Información Clínica MORFOLOGÍA DE SANGRE PERIFÉRICA INTRODUCCION
 MORFOLOGÍA DE SANGRE PERIFÉRICA INTRODUCCION La morfología de sangre periférica (MSP) es una extensión teñida de sangre periférica obtenida a partir de la punción digital directa. El estudio microscópico
MORFOLOGÍA DE SANGRE PERIFÉRICA INTRODUCCION La morfología de sangre periférica (MSP) es una extensión teñida de sangre periférica obtenida a partir de la punción digital directa. El estudio microscópico
La fórmula leucocitaria, junto con los recuentos celulares siguen siendo pruebas de gran importancia biodiagnóstica.
 SERVICIO DE LABORATORIO 29 DE 7 7 LEUCOGRAMA 7.1 GENERALIDADES La fórmula leucocitaria, junto con los recuentos celulares siguen siendo pruebas de gran importancia biodiagnóstica. 7.2 OBJETIVO Con ella
SERVICIO DE LABORATORIO 29 DE 7 7 LEUCOGRAMA 7.1 GENERALIDADES La fórmula leucocitaria, junto con los recuentos celulares siguen siendo pruebas de gran importancia biodiagnóstica. 7.2 OBJETIVO Con ella
Insuficiencia de hierro...
 Insuficiencia de hierro... TFR Un diagnóstico eficaz de su Receptor Soluble de Transferrina. Qué es el Receptor Soluble de Transferrina (TFR)? Es una proteína de transmembrana presente en todas las células.
Insuficiencia de hierro... TFR Un diagnóstico eficaz de su Receptor Soluble de Transferrina. Qué es el Receptor Soluble de Transferrina (TFR)? Es una proteína de transmembrana presente en todas las células.
Guía de Práctica Clínica GPC. Diagnóstico y Tratamiento del Síndrome Mielodisplásico
 Guía de Práctica Clínica GPC Diagnóstico y Tratamiento del Síndrome Mielodisplásico Guía de Referencia Rápida Catalogo Maestro de Guías de Práctica Clínica: IMSS-407-10 Guía de Referencia Rápida D46 Síndromes
Guía de Práctica Clínica GPC Diagnóstico y Tratamiento del Síndrome Mielodisplásico Guía de Referencia Rápida Catalogo Maestro de Guías de Práctica Clínica: IMSS-407-10 Guía de Referencia Rápida D46 Síndromes
APLICACIONES DE LA CITOMETRIA DE FLUJO EN ONCOHEMATOLOGIA
 APLICACIONES DE LA CITOMETRIA DE FLUJO EN ONCOHEMATOLOGIA Bioquimica Esp.en Hematologia Susana Rubiolo Citometriade Flujo Estudia suspensiones celulares u otras particulas biologicas Analiza en forma rápida
APLICACIONES DE LA CITOMETRIA DE FLUJO EN ONCOHEMATOLOGIA Bioquimica Esp.en Hematologia Susana Rubiolo Citometriade Flujo Estudia suspensiones celulares u otras particulas biologicas Analiza en forma rápida
La enfermedad hepática
 6 6.Prevención de la salud La enfermedad hepática El término enfermedad hepática se aplica a muchas enfermedades y trastornos que hacen que el hígado funcione mal o no funcione. 7 Síntomas En la enfermedad
6 6.Prevención de la salud La enfermedad hepática El término enfermedad hepática se aplica a muchas enfermedades y trastornos que hacen que el hígado funcione mal o no funcione. 7 Síntomas En la enfermedad
GRUPO EUROPEO PARA LA CARACTERIZACION DE LAS LEUCEMIAS AGUDAS (EGIL) DEFINE GRUPOS DE RIESGO/ PRONOSTICO ESPECIFICOS
 CLASIFICACIÓN N INMUNOLÓGICA: GRUPO EUROPEO PARA LA CARACTERIZACION DE LAS LEUCEMIAS AGUDAS (EGIL) DEFINE GRUPOS DE RIESGO/ PRONOSTICO ESPECIFICOS LLA-B LLA-T LLA-B LOS LINFOBLASTOS SON TdT POSITIVOS HLA-DR
CLASIFICACIÓN N INMUNOLÓGICA: GRUPO EUROPEO PARA LA CARACTERIZACION DE LAS LEUCEMIAS AGUDAS (EGIL) DEFINE GRUPOS DE RIESGO/ PRONOSTICO ESPECIFICOS LLA-B LLA-T LLA-B LOS LINFOBLASTOS SON TdT POSITIVOS HLA-DR
2ª edición. Atlas de hemocitología veterinaria LA EDITORIAL DE LOS VETERINARIOS ANIMALES DE COMPAÑÍA CARACTERÍSTICAS TÉCNICAS
 LA EDITORIAL DE LOS VETERINARIOS ANIMALES DE COMPAÑÍA Atlas de hemocitología veterinaria 2ª edición Incluye médula ósea y nuevos casos clínicos Dirigido a veterinarios, estudiantes, profesores y profesionales
LA EDITORIAL DE LOS VETERINARIOS ANIMALES DE COMPAÑÍA Atlas de hemocitología veterinaria 2ª edición Incluye médula ósea y nuevos casos clínicos Dirigido a veterinarios, estudiantes, profesores y profesionales
Técnicas utilizadas en el estudio de las cromosomopatías y del cáncer. Aplicaciones clínicas.
 Técnicas utilizadas en el estudio de las cromosomopatías y del cáncer. Aplicaciones clínicas. El análisis cromosómico ha proporcionado un conocimiento básico de los cambios genéticos responsables de las
Técnicas utilizadas en el estudio de las cromosomopatías y del cáncer. Aplicaciones clínicas. El análisis cromosómico ha proporcionado un conocimiento básico de los cambios genéticos responsables de las
La Sangre. Universidad Autónoma del Estado de Morelos Escuela de Técnicos Laboratoristas Anatomía y Fisiología
 La Sangre Universidad Autónoma del Estado de Morelos Escuela de Técnicos Laboratoristas Anatomía y Fisiología Alumna: Carpinteiro Morales Alexa Karina Semestre y grupo: 5to A2 Cuestionario 1.- Qué es la
La Sangre Universidad Autónoma del Estado de Morelos Escuela de Técnicos Laboratoristas Anatomía y Fisiología Alumna: Carpinteiro Morales Alexa Karina Semestre y grupo: 5to A2 Cuestionario 1.- Qué es la
Alteraciones multifocales de la señal de la médula ósea de los cuerpos vertebrales en RM. Diagnóstico diferencial
 Alteraciones multifocales de la señal de la médula ósea de los cuerpos vertebrales en RM. Diagnóstico diferencial Poster no.: S-0447 Congreso: SERAM 2014 Tipo del póster: Presentación Electrónica Educativa
Alteraciones multifocales de la señal de la médula ósea de los cuerpos vertebrales en RM. Diagnóstico diferencial Poster no.: S-0447 Congreso: SERAM 2014 Tipo del póster: Presentación Electrónica Educativa
ULTRASONIDO DEL BAZO Análisis de 40 casos. Dra. Alicia López Bermúdez
 ULTRASONIDO DEL BAZO Análisis de 40 casos Dra. Alicia López Bermúdez www.acupunturaveterinariacr.com Es un órgano linfoide secundario. Constituido por linfocitos, células plasmáticas, sistema retículoendotelial,
ULTRASONIDO DEL BAZO Análisis de 40 casos Dra. Alicia López Bermúdez www.acupunturaveterinariacr.com Es un órgano linfoide secundario. Constituido por linfocitos, células plasmáticas, sistema retículoendotelial,
MIELOMA MÚLTIPLE. El mieloma múltiple se caracteriza por una proliferación incontrolada de
 MIELOMA MÚLTIPLE INTRODUCCIÓN El mieloma múltiple se caracteriza por una proliferación incontrolada de células plasmáticas, células linfoides B en el último estadio de maduración, en la médula ósea. Esta
MIELOMA MÚLTIPLE INTRODUCCIÓN El mieloma múltiple se caracteriza por una proliferación incontrolada de células plasmáticas, células linfoides B en el último estadio de maduración, en la médula ósea. Esta
Competencias con las que se relacionan en orden de importancia
 UNIVERSIDAD NACIONAL AUTÓNOMA DE MÉXICO FACULTAD DE MEDICINA PLANDEESTUDIOSDELALICENCIATURA DEMEDICOCIRUJANO Programa de la asignatura Denominación: Hematología Rotación A Clave: Semestre: Sexto Área:
UNIVERSIDAD NACIONAL AUTÓNOMA DE MÉXICO FACULTAD DE MEDICINA PLANDEESTUDIOSDELALICENCIATURA DEMEDICOCIRUJANO Programa de la asignatura Denominación: Hematología Rotación A Clave: Semestre: Sexto Área:
LA LEUCEMIA. Andrea Nimo Mallo, 1ºB BACH
 LA LEUCEMIA Andrea Nimo Mallo, 1ºB BACH Índice Qué es la leucemia? Animación sobre cómo se produce la leucemia. Clasificación. Causas. Síntomas. Diagnóstico. Tratamiento. Prevención. Vídeo resumen sobre
LA LEUCEMIA Andrea Nimo Mallo, 1ºB BACH Índice Qué es la leucemia? Animación sobre cómo se produce la leucemia. Clasificación. Causas. Síntomas. Diagnóstico. Tratamiento. Prevención. Vídeo resumen sobre
HEMATOLOGIA II 2015 ONCOHEMATOLOGÍA LEUCEMIAS LINFOBLÁSTICAS AGUDAS. Cátedra Hematología Dra. Margarita Bragós
 HEMATOLOGIA II 2015 ONCOHEMATOLOGÍA LEUCEMIAS LINFOBLÁSTICAS AGUDAS Cátedra Hematología Dra. Margarita Bragós LEUCEMIAS Leucemia Linfoblástica Aguda La leucemia linfoblástica aguda (LLA) (así como el linfoma
HEMATOLOGIA II 2015 ONCOHEMATOLOGÍA LEUCEMIAS LINFOBLÁSTICAS AGUDAS Cátedra Hematología Dra. Margarita Bragós LEUCEMIAS Leucemia Linfoblástica Aguda La leucemia linfoblástica aguda (LLA) (así como el linfoma
Bioq Especialista María Cecilia Moyano Laboratorio del Hospital Misericordia Nuevo Siglo Docente en la carrera de Especialización Bioquímica Clínica
 REACCIONES LEUCEMOIDES EN NEONATOLOGÍA Bioq Especialista María Cecilia Moyano Laboratorio del Hospital Misericordia Nuevo Siglo Docente en la carrera de Especialización Bioquímica Clínica Área Hematología
REACCIONES LEUCEMOIDES EN NEONATOLOGÍA Bioq Especialista María Cecilia Moyano Laboratorio del Hospital Misericordia Nuevo Siglo Docente en la carrera de Especialización Bioquímica Clínica Área Hematología
Antecedentes Personales
 Caso Cerrado Antecedentes Personales Varón de 23 años sin AP de interés Residente en provincia de Barcelona Hace 2 años diagnosticado de LES Historia Actual Al mes: fiebre 39º con sudoración SE Hb 8,6
Caso Cerrado Antecedentes Personales Varón de 23 años sin AP de interés Residente en provincia de Barcelona Hace 2 años diagnosticado de LES Historia Actual Al mes: fiebre 39º con sudoración SE Hb 8,6
INFORMACIÓN SOBRE LINFOMA NO HODGKIN
 INFORMACIÓN SOBRE LINFOMA NO HODGKIN QUÉ ES EL LINFOMA NO HODGKIN? El linfoma no Hodgkin (LNH) es un tipo de cáncer del sistema linfático que afecta a los linfocitos, en el cual se presenta un crecimiento
INFORMACIÓN SOBRE LINFOMA NO HODGKIN QUÉ ES EL LINFOMA NO HODGKIN? El linfoma no Hodgkin (LNH) es un tipo de cáncer del sistema linfático que afecta a los linfocitos, en el cual se presenta un crecimiento
El cáncer es actualmente un grupo de enfermedades, cada una de ellas con su propio nombre y con diferente pronóstico y tratamiento.
 El cáncer es actualmente un grupo de enfermedades, cada una de ellas con su propio nombre y con diferente pronóstico y tratamiento. La causa por la que aparece el cáncer en los niños es desconocida y no
El cáncer es actualmente un grupo de enfermedades, cada una de ellas con su propio nombre y con diferente pronóstico y tratamiento. La causa por la que aparece el cáncer en los niños es desconocida y no
Citometría de Flujo. El citómetro de flujo consta de tres sistemas principales (Figura N 1):
 Citometría de Flujo La citometría de flujo es una técnica multiparamétrica que permite estudiar propiedades físicas y biológicas de células en una suspensión fluida. El desarrollo de los anticuerpos monoclonales
Citometría de Flujo La citometría de flujo es una técnica multiparamétrica que permite estudiar propiedades físicas y biológicas de células en una suspensión fluida. El desarrollo de los anticuerpos monoclonales
Cuarto encuentro de Final de Residencia Societat Catalana d Hematologia i Hemoteràpia Marzo 2016
 Cuarto encuentro de Final de Residencia Societat Catalana d Hematologia i Hemoteràpia Marzo 2016 Dra Luz Muñoz Servicio de Laboratorio Corsorcio Universitario Parc Taulí, Sabadell SLPC-T Conjunto de enfermedades
Cuarto encuentro de Final de Residencia Societat Catalana d Hematologia i Hemoteràpia Marzo 2016 Dra Luz Muñoz Servicio de Laboratorio Corsorcio Universitario Parc Taulí, Sabadell SLPC-T Conjunto de enfermedades
. ALGO MÁS QUE UNA CREMITA
 . ALGO MÁS QUE UNA CREMITA ATENEO CENTRAL 10 06 2014 SERVICIO DE DERMATOLOGÍA HPGPE PACIENTE 1 Edad: 9 años Fecha de consulta: 17/12/2013 AP: RNPT (34S)PAEG. Internado en neo por ictericia y para recuperación
. ALGO MÁS QUE UNA CREMITA ATENEO CENTRAL 10 06 2014 SERVICIO DE DERMATOLOGÍA HPGPE PACIENTE 1 Edad: 9 años Fecha de consulta: 17/12/2013 AP: RNPT (34S)PAEG. Internado en neo por ictericia y para recuperación
LEUCEMIAS EN EL ANCIANO UN DILEMA POR RESOLVER
 LEUCEMIAS EN EL ANCIANO UN DILEMA POR RESOLVER CLASIFICACIÓN DE LAS LEUCEMIAS MIELOIDES LINFOIDES AGUDAS LEUCEMIA AGUDA MIELOBLÁSTICA LEUCEMIA AGUDA LINFOBLÁSTICA CRÓNICAS LEUCEMIA MIELOIDE CRÓNICA LEUCEMIA
LEUCEMIAS EN EL ANCIANO UN DILEMA POR RESOLVER CLASIFICACIÓN DE LAS LEUCEMIAS MIELOIDES LINFOIDES AGUDAS LEUCEMIA AGUDA MIELOBLÁSTICA LEUCEMIA AGUDA LINFOBLÁSTICA CRÓNICAS LEUCEMIA MIELOIDE CRÓNICA LEUCEMIA
Club de Linfomas Santiago de Compostela 3 octubre Augusto Alvarez Servicio de Anatomía Patológica CHUAC
 Club de Linfomas Santiago de Compostela 3 octubre 2011 Augusto Alvarez Servicio de Anatomía Patológica CHUAC VARÓN DE 22 AÑOS. CLINICA: PLACA ECZEMATOSA DISCOIDE DE 2 CMS DE DIAMETRO, EN BRAZO DERECHO
Club de Linfomas Santiago de Compostela 3 octubre 2011 Augusto Alvarez Servicio de Anatomía Patológica CHUAC VARÓN DE 22 AÑOS. CLINICA: PLACA ECZEMATOSA DISCOIDE DE 2 CMS DE DIAMETRO, EN BRAZO DERECHO
BIOPSIA DE MEDULA OSEA EN LOS LINFOMAS. Sergio Serrano Hospital del Mar-UAB
 BIOPSIA DE MEDULA OSEA EN LOS LINFOMAS Sergio Serrano Hospital del Mar-UAB BIOPSIA DE MEDULA OSEA EN LOS LINFOMAS Extensión de la enfermedad Respuesta al tratamiento Diagnóstico BIOPSIA DE MEDULA OSEA
BIOPSIA DE MEDULA OSEA EN LOS LINFOMAS Sergio Serrano Hospital del Mar-UAB BIOPSIA DE MEDULA OSEA EN LOS LINFOMAS Extensión de la enfermedad Respuesta al tratamiento Diagnóstico BIOPSIA DE MEDULA OSEA
Seminario para pacientes y familiares con mieloma múltiple. Maite Cibeira 19 de Octubre de 2015
 Seminario para pacientes y familiares con mieloma múltiple Maite Cibeira 19 de Octubre de 2015 HABLEMOS DEL MIELOMA MÚLTIPLE Qué es? Es frecuente? Cuál es la causa? Cómo se manifiesta? Cómo se diagnostica?
Seminario para pacientes y familiares con mieloma múltiple Maite Cibeira 19 de Octubre de 2015 HABLEMOS DEL MIELOMA MÚLTIPLE Qué es? Es frecuente? Cuál es la causa? Cómo se manifiesta? Cómo se diagnostica?
Enfermedad renal crónica
 Enfermedad renal crónica Introducción La médula ósea es el tejido esponjoso dentro de todos sus huesos, incluidos la cadera y los huesos del muslo. La médula ósea es como una fábrica que produce diferentes
Enfermedad renal crónica Introducción La médula ósea es el tejido esponjoso dentro de todos sus huesos, incluidos la cadera y los huesos del muslo. La médula ósea es como una fábrica que produce diferentes
Dos tipos de DEFENSAS: 1.- EXTERNAS O PASIVAS: 2.- INESPECÍFICAS: - Estructurales - Mecánicas - Bioquímicas - Ecológicas
 (Inmunología I) Dos tipos de DEFENSAS: 1.- EXTERNAS O PASIVAS: - Estructurales - Mecánicas - Bioquímicas - Ecológicas 2.- INESPECÍFICAS: - Inflamación - Fagocitos (respuesta celular) - Inmune (respuesta
(Inmunología I) Dos tipos de DEFENSAS: 1.- EXTERNAS O PASIVAS: - Estructurales - Mecánicas - Bioquímicas - Ecológicas 2.- INESPECÍFICAS: - Inflamación - Fagocitos (respuesta celular) - Inmune (respuesta
Estudio de Linfomas No Hodgkin y Neoplasias de Celulas Plasmaticas por Citometria de Flujo. Primera Parte. Conceptos Generales
 Estudio de Linfomas No Hodgkin y Neoplasias de Celulas Plasmaticas por Citometria de Flujo Primera Parte Conceptos Generales Bioq. Mariela B. Monreal Introducción Aportes de la Citometria de Flujo en el
Estudio de Linfomas No Hodgkin y Neoplasias de Celulas Plasmaticas por Citometria de Flujo Primera Parte Conceptos Generales Bioq. Mariela B. Monreal Introducción Aportes de la Citometria de Flujo en el
COMITÉ REGIONAL DE CONTROL Y VIGILANCIA PARA EL HANTA
 COMITÉ REGIONAL DE CONTROL Y VIGILANCIA PARA EL HANTA SINDROME PULMONAR POR HANTA VIRUS Por orden del SEREMI Res. Nº 0476/05 T.M. EDUARDO RETAMALES CASTELLETTO INSTITUTO DE SALUD PÚBLICA DE CHILE ANTECEDENTES
COMITÉ REGIONAL DE CONTROL Y VIGILANCIA PARA EL HANTA SINDROME PULMONAR POR HANTA VIRUS Por orden del SEREMI Res. Nº 0476/05 T.M. EDUARDO RETAMALES CASTELLETTO INSTITUTO DE SALUD PÚBLICA DE CHILE ANTECEDENTES
Tumores más Frecuentes en Pediatría. Dr. Mauro A. Valdivieso Calderón HGM 2009
 Tumores más Frecuentes en Pediatría Dr. Mauro A. Valdivieso Calderón HGM 2009 Tumores más frecuentes en pediatría Leucemia Linfoma Tumores del SNC Neuroblastoma Tumores mas frecuentes en pediatría Tumor
Tumores más Frecuentes en Pediatría Dr. Mauro A. Valdivieso Calderón HGM 2009 Tumores más frecuentes en pediatría Leucemia Linfoma Tumores del SNC Neuroblastoma Tumores mas frecuentes en pediatría Tumor
TRASTORNOS DE SANGRADOS.
 1 TRASTORNOS DE SANGRADOS. Una persona que sangra no únicamente puede tener como causa de su sangrado algún defecto de la coagulación, sino también de las plaquetas ó de vasos sanguíneos, de modo que lo
1 TRASTORNOS DE SANGRADOS. Una persona que sangra no únicamente puede tener como causa de su sangrado algún defecto de la coagulación, sino también de las plaquetas ó de vasos sanguíneos, de modo que lo
Neoplasias Hematológicas Leucemias y Linfomas
 Neoplasias Hematológicas Leucemias y Linfomas Dr Jose M. Ojeda F. Fac Medicina UDP CANCER Complejo conjunto de enfermedades Enfermedad multifactorial.ocurre en etapas Afecta a células somáticas de nuestro
Neoplasias Hematológicas Leucemias y Linfomas Dr Jose M. Ojeda F. Fac Medicina UDP CANCER Complejo conjunto de enfermedades Enfermedad multifactorial.ocurre en etapas Afecta a células somáticas de nuestro
CUÁLES SON LAS MANIFESTACIONES CLÍNICAS?
 CÁNCER INFORMACIÓN BÁSICA SOBRE TIPOLOGÍA, SINTOMATOLOGÍA Y TRATAMIENTOS DISPONIBLES 1 QUÉ ES EL CÁNCER? Se denomina cáncer al proceso de crecimiento y diseminación descontrolados de células en alguna
CÁNCER INFORMACIÓN BÁSICA SOBRE TIPOLOGÍA, SINTOMATOLOGÍA Y TRATAMIENTOS DISPONIBLES 1 QUÉ ES EL CÁNCER? Se denomina cáncer al proceso de crecimiento y diseminación descontrolados de células en alguna
SINDROMES LINFOPROLIFERATIVOS CRÓNICOS
 SINDROMES LINFOPROLIFERATIVOS CRÓNICOS Linfocitos B Los linfocitos B derivan de una célula germinal linfoide pluripotente. Adquieren su competencia inmunológica en la médula ósea independientemente de
SINDROMES LINFOPROLIFERATIVOS CRÓNICOS Linfocitos B Los linfocitos B derivan de una célula germinal linfoide pluripotente. Adquieren su competencia inmunológica en la médula ósea independientemente de
PEM 39 (Dr. Ramón y Cajal) 18/12/2014 Antonio Bechara Ghobril LINFOMAS NO HODGKIN
 LINFOMAS NO HODGKIN Clasificación Este tipo de linfomas tiene una historia muy larga y complicada porque de su estudio se han encargado patólogos, clínicos y moleculares que, durante décadas, han formulado
LINFOMAS NO HODGKIN Clasificación Este tipo de linfomas tiene una historia muy larga y complicada porque de su estudio se han encargado patólogos, clínicos y moleculares que, durante décadas, han formulado
Tema 2.- Bases morfológicas del Sistema Inmunológico. Células, tejidos y órganos linfoides
 Tema 2.- Bases morfológicas del Sistema Inmunológico. Células, tejidos y órganos linfoides 1.- Células presentadoras de antígenos: Capturan y exponen los antígenos 2.- Células específicas: Reconocen y
Tema 2.- Bases morfológicas del Sistema Inmunológico. Células, tejidos y órganos linfoides 1.- Células presentadoras de antígenos: Capturan y exponen los antígenos 2.- Células específicas: Reconocen y
LA CITOGENÉTICA EN LOS LINFOMAS. UNA PERSPECTIVA DESDE LA EXPERIENCIA
 LA CITOGENÉTICA EN LOS LINFOMAS. UNA PERSPECTIVA DESDE LA EXPERIENCIA Blanca Espinet Citogenètica Molecular, Servei de Patologia IMIM-Hospital del Mar CONSIDERACIONES TÉCNICAS Es esencial estudiar el tejido
LA CITOGENÉTICA EN LOS LINFOMAS. UNA PERSPECTIVA DESDE LA EXPERIENCIA Blanca Espinet Citogenètica Molecular, Servei de Patologia IMIM-Hospital del Mar CONSIDERACIONES TÉCNICAS Es esencial estudiar el tejido
SOCIEDAD VENEZOLANA DE HEMATOLOGIA
 HEMATOLOGÍA DEFINICIÓN DE LA ESPECIALIDAD Y CAMPO DE ACCIÓN Dra. Dalia Velásquez de Lara Jefa del servicio de Hematología y banco de Sangre Hospital Universitario de Caracas Vicepresidenta Junta Directiva
HEMATOLOGÍA DEFINICIÓN DE LA ESPECIALIDAD Y CAMPO DE ACCIÓN Dra. Dalia Velásquez de Lara Jefa del servicio de Hematología y banco de Sangre Hospital Universitario de Caracas Vicepresidenta Junta Directiva
Los Leucocitos 10/10/2016. Recuento. Formula Leucocitaria. GRANULOCITOS, POLIMORFONUCLEARES ó POLINUCLEARES (PMN ó PN) ó SEGMENTADOS
 LEUCOCITOS Los Leucocitos Recuento. Formula Leucocitaria. Los leucocitos son células nucleadas, cuyo número oscila entre 4.000 y 11.000 por microlitro(μl) de sangre (4-11 x 10 3 /mm 3 ó μl) (si< Leucopenia,
LEUCOCITOS Los Leucocitos Recuento. Formula Leucocitaria. Los leucocitos son células nucleadas, cuyo número oscila entre 4.000 y 11.000 por microlitro(μl) de sangre (4-11 x 10 3 /mm 3 ó μl) (si< Leucopenia,
REGIÓN DE MURCIA - Mujeres
 C00. Tumor maligno del labio C0. Tumor maligno de la base de la lengua C02. Tumor maligno de otras partes y de las no especificadas de la lengua 5 C03. Tumor maligno de la encía C04. Tumor maligno del
C00. Tumor maligno del labio C0. Tumor maligno de la base de la lengua C02. Tumor maligno de otras partes y de las no especificadas de la lengua 5 C03. Tumor maligno de la encía C04. Tumor maligno del
TRASTORNOS HEMORRAGICOS: Alteraciones plaquetarias. Alteraciones del sistema de coagulación. Compromiso de la fibrinolisis.
 TRASTORNOS HEMORRAGICOS: Alteraciones plaquetarias. Alteraciones del sistema de coagulación. Compromiso de la fibrinolisis. TABLA DE VALORES NORMALES DE LOS EXAMENES DE SANGRE MAS FRECUENTEMENTE UTILIZADOS
TRASTORNOS HEMORRAGICOS: Alteraciones plaquetarias. Alteraciones del sistema de coagulación. Compromiso de la fibrinolisis. TABLA DE VALORES NORMALES DE LOS EXAMENES DE SANGRE MAS FRECUENTEMENTE UTILIZADOS
Curso Presencial. Técnicas de Reconocimiento Morfológico en Hematología
 Curso Presencial Técnicas de Reconocimiento Morfológico en Hematología Información General Versión: 12ª (2016) Modalidad: Duración Total: Presencial 51 horas Fecha de Inicio: 30 de julio de 2016 Fecha
Curso Presencial Técnicas de Reconocimiento Morfológico en Hematología Información General Versión: 12ª (2016) Modalidad: Duración Total: Presencial 51 horas Fecha de Inicio: 30 de julio de 2016 Fecha
Antonio Ferrández Izquierdo Servicio de Anatomía Patológica Hospital Clínico Departamento de Patología Universidad de Valencia
 Antonio Ferrández Izquierdo Servicio de Anatomía Patológica Hospital Clínico Departamento de Patología Universidad de Valencia Caso nº5 -Mujer de 81 años -Acude a Urgencias por lesión cutánea en rodilla
Antonio Ferrández Izquierdo Servicio de Anatomía Patológica Hospital Clínico Departamento de Patología Universidad de Valencia Caso nº5 -Mujer de 81 años -Acude a Urgencias por lesión cutánea en rodilla
Consideraciones Generales
 CURSO DE ORTOPEDIA ONCOLÓGICA Consideraciones Generales Dr. Carlos E. Cuervo Lozano Dr. Azael Calderón RII Terminología Hiperplasia.- Aumento y acumulación de células debido a un estímulo Metaplasia.-
CURSO DE ORTOPEDIA ONCOLÓGICA Consideraciones Generales Dr. Carlos E. Cuervo Lozano Dr. Azael Calderón RII Terminología Hiperplasia.- Aumento y acumulación de células debido a un estímulo Metaplasia.-
Incidencia /100.000/año
 CAPÍTULO 65 NEOPLASIAS HEMATOLÓGICAS Inmaculada Rodríguez Díaz-Regañón Introducción Las neoplasias hematológicas forman un grupo de enfermedades que provienen de la expansión clonal de células hematopoyéticas,
CAPÍTULO 65 NEOPLASIAS HEMATOLÓGICAS Inmaculada Rodríguez Díaz-Regañón Introducción Las neoplasias hematológicas forman un grupo de enfermedades que provienen de la expansión clonal de células hematopoyéticas,
Guía de Referencia Rápida. Diagnóstico y Tratamiento del Síndrome de Falla Medular en Edad Pediátrica en Tercer Nivel de Atención
 Guía de Referencia Rápida Diagnóstico y Tratamiento del Síndrome de Falla Medular en Edad Pediátrica en Tercer Nivel de Atención Guía de Referencia Rápida D60 Aplasia Adquirida, Exclusiva de la Serie Roja
Guía de Referencia Rápida Diagnóstico y Tratamiento del Síndrome de Falla Medular en Edad Pediátrica en Tercer Nivel de Atención Guía de Referencia Rápida D60 Aplasia Adquirida, Exclusiva de la Serie Roja
Este capítulo brinda información fantástica sobre los conceptos básicos acerca de las células madre de médula ósea.
 Este capítulo brinda información fantástica sobre los conceptos básicos acerca de las células madre de médula ósea. Sobreviviente de trasplante de médula ósea y sangre Capítulo 4 Conceptos básicos sobre
Este capítulo brinda información fantástica sobre los conceptos básicos acerca de las células madre de médula ósea. Sobreviviente de trasplante de médula ósea y sangre Capítulo 4 Conceptos básicos sobre
ESTUDIO HISTOPATOLOGICO BASICO DE LA MEDULA OSEA
ESTUDIO HISTOPATOLOGICO BASICO DE LA MEDULA OSEA 1. Introducción. Estudio morfológico y funcional de la médula ósea. Patologia no neoplásica 2. Inmunohistoquímica del tejido hematopoyético 3. Síndromes
ESTUDIO HISTOPATOLOGICO BASICO DE LA MEDULA OSEA 1. Introducción. Estudio morfológico y funcional de la médula ósea. Patologia no neoplásica 2. Inmunohistoquímica del tejido hematopoyético 3. Síndromes
DOCUMENTO DE INDICACIONES DE BÚSQUEDA DE DONANTES NO EMPARENTADOS. COMITÉ DE EXPERTOS DE TPH
 DOCUMENTO DE INDICACIONES DE BÚSQUEDA DE DONANTES NO EMPARENTADOS. COMITÉ DE EXPERTOS DE TPH SUBCOMISIÓN DE TRASPLANTE DE PROGENITORES HEMOPOYÉTICOS 4 de febrero de 2014 COMISIÓN DE TRASPLANTES 18 de marzo
DOCUMENTO DE INDICACIONES DE BÚSQUEDA DE DONANTES NO EMPARENTADOS. COMITÉ DE EXPERTOS DE TPH SUBCOMISIÓN DE TRASPLANTE DE PROGENITORES HEMOPOYÉTICOS 4 de febrero de 2014 COMISIÓN DE TRASPLANTES 18 de marzo
Poblaciones celulares normales de sangre y médula ósea
 Poblaciones celulares normales de sangre y médula ósea TM. Cristopher Palma. Ref: - Leach M., Drummond M., Doig A., Practical Flow Cytometry in Haematology Diagnosis. 2013 - E.G. van Lochem et. al. Immunophenotypic
Poblaciones celulares normales de sangre y médula ósea TM. Cristopher Palma. Ref: - Leach M., Drummond M., Doig A., Practical Flow Cytometry in Haematology Diagnosis. 2013 - E.G. van Lochem et. al. Immunophenotypic
MC. Edgar Alejandro Turrubiartes Martínez Serie blanca
 Serie blanca Caso 1 La enfermera de una universidad llevó a una estudiante de primer año de 18 años de edad a la sala de urgencia por dolor abdominal interno. No tenía antecedente de enfermedades previas,
Serie blanca Caso 1 La enfermera de una universidad llevó a una estudiante de primer año de 18 años de edad a la sala de urgencia por dolor abdominal interno. No tenía antecedente de enfermedades previas,
LINFADENOPATÍAS. Dra. Graciela Grosso Junio 2013
 LINFADENOPATÍAS Dra. Graciela Grosso Junio 2013 Linfadenopatías Ganglios linfáticos anormales 1 ó + ganflios con diámetro > 1cm ganglio epitroclear > 5 mm de diámetro cualquier ganglio palpable en regiones
LINFADENOPATÍAS Dra. Graciela Grosso Junio 2013 Linfadenopatías Ganglios linfáticos anormales 1 ó + ganflios con diámetro > 1cm ganglio epitroclear > 5 mm de diámetro cualquier ganglio palpable en regiones
